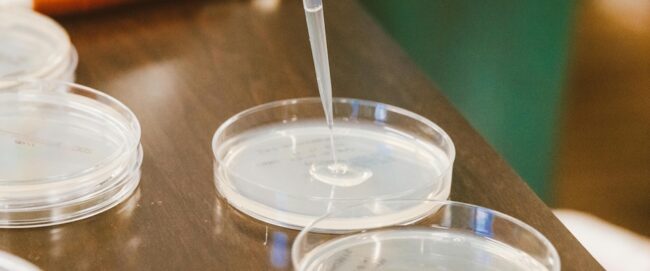

It was my pleasure to get to write on the past, present, (and hopeful future) of high school science fairs for Asterisk. What I carried out of the lab and what enriched my life didn’t have much to do with the scientific method of “explore, wonder, hypothesize, test, repeat.” Instead, the most valuable things I… Read More